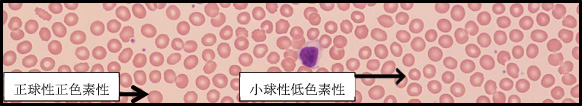

=== 随筆・その他 ===
|
| 頭痛とビタミンB12欠乏 |
東区・郡元支部
(デイジークリニック) 武元 良整 |
|
内科外来では貧血が原因で頭痛を訴える事はよくあります。困るのは,貧血がなくて頭痛がある時です。
9年間悩まされた頭痛の原因がビタミンB12低値と考えられ,その補充により頭痛が消失した症例を紹介します。2例目は「めまいやふらふら感そして頭痛」で来院,ビタミンB12の静注で頭痛が消失した例です。2例とも特徴は貧血は認めず,頭痛などを主訴に来院という事です。
症 例 1:21歳,女性
主 訴:13歳からの頭痛
背 景:中学1年から部活はソフトボール部。現在は栄養士として勤務。貧血歴なし。アレルギー歴なし。6カ月前の健診でも異常なし。非喫煙・飲酒せず。
身体計測:身長165cm,体重67.3kg,BMI:24.7,血圧112/59
病 歴:中学1年生から頭痛のため脳外科通院中。脳外科的には頭痛を来すような器質的疾患なし。頭痛時には解熱鎮痛剤を長年常用している。便通良好。
末梢血検査
| 検査結果 |
| RBC:450/μL,Hb:13.6g/dL,MCV(mean corpuscular volume:平均赤血球容積):92.2fL,MCH(mean corpuscular hemoglobin:平均赤血球血色素値):30.2pg,PLT(血小板数):29.2万/μL |
臨床経過:末梢血液像では小球性低色素性が明らかなため(赤血球像の大小不同1+あり,多染性1+)(図1),鉄欠乏性貧血やスポーツ貧血も疑い血清フェリチン値(45.2ng/ml)や血清ハプトグロビンを検査するも正常範囲。赤血球形態から軽度大球性(MCV:92.2)にてビタミンB12欠乏を疑い検査。ビタミンB12:220pg/ml,葉酸:5.3ng/ml,両者とも低目で要補充と考えた。葉酸は1カ月内服継続。連日の頭痛対策としてビタミンB12を静注施行。5-6回の静注で高度の頭痛は軽減するもまだ頭痛あり,9回目の静注後から鎮痛剤を内服せずに過ごせるようになった。
漢方的には,お血を腹証で認め,桂枝茯苓丸と五苓散の内服を継続中。本人は漢方内服よりもビタミンB12静注後に頭痛が改善したと感じている。
症 例 2:35歳,女性
主 訴:めまい,たちくらみ,臥床していてもふらふら,頭痛,疲れやすい。
背 景:著患なく,アルコール歴もなし健診でも正常範囲。体重40kg。
既 往 歴:慢性皮疹で皮膚科通院中。アレルギー歴なし。
末梢血検査
| 検査結果 |
| RBC:442/μL,Hb:13.6g/dL,MCV(mean corpuscular volume:平均赤血球容積):91.4fL,MCH(mean corpuscular hemoglobin:平均赤血球血色素値):30.8pg,PLT(血小板数):24.5万/μL |
血清ビタミンB12値は173pg/mL(基準値180-914)と低値,葉酸値は7.6ng/ml(基準値4以上)
臨床経過:血清ビタミンB12値は基準値以下で,症状も強いことからビタミンB12静注にて治療を開始したところ,3回目終了時から頭痛消失,5-6回目の静注でたちくらみ改善。10回の静注後から1カ月後にビタミンB12値を測定すると245pg/mLと依然低目にてビタミンB12を内服継続。その3カ月後の再検値は477pg/mLと回復。
漢方的には,腹証にて気虚+水滞を認め,補中益気湯と五苓散の内服を継続。慢性下痢もあったため,腸管から慢性的にビタミンB12の吸収不良があった可能性も考えられました。
|
図1 末梢血液像:RBC形態は大小不同1+あり,多染性1+
(末梢血液画像は鹿児島市医師会臨床検査センター血液検査室へ依頼し撮影いただきました) |
まとめ
症例1はビタミンB12補充後の頭痛消失例。頭痛はビタミンB12および葉酸が低値であった事に起因するのではないかと考えました。
症例2は「めまい・たちくらみ」の症状で来院。ビタミンB12の静注で頭痛は軽快。その後,血中濃度の維持のため内服継続しております。
頭痛とビタミンB12低値との関連:過去5年間にHb値が12.0以上(貧血なし)かつ,ビタミンB12低下例(180pg/ml以下)は53例でした。その中で5例が頭痛を主訴に来院。つまり,貧血なし,頭痛ありそしてビタミンB12が低値の症例の頻度は53例中5例(9.5%)と多くはありません。しかし,毎日の頭痛に鎮痛剤を多用する症例ではビタミンB12測定を考慮する事は有用と思われました。ビタミンB12,葉酸ともに発汗などにより夏場の消耗が激しいビタミンB群でもあります。オーバートレーニングのある場合など問診での確認が必要です。
おわりに
ビタミンB12低下の臨床症状は多様で,次の8項目が知られています1)。1.疲労,たちくらみ,2.動悸,呼吸速迫,3.顔面蒼白,4.舌痛,5.出血傾向,6.胃不快と体重減少,7.便秘や下痢,8.頭痛。貧血の臨床症状は「疲れやすい」「息切れ」「顔色がわるい」など曖昧です。貧血の診断は症状の聞き取り方よりも検査値の解釈にページを割かれています2)。一般内科外来では,検査の前に頭痛などの訴えから「ビタミンB12の不足」を読み取れるような前述8項目の問診も大事になってきます。そして,疑わしければ,ビタミンB12の検査が診断に有用です。
文 献
1.武元良整:健診で貧血を指摘されて(1)~2年間,自覚症状のなかった鉄欠乏性貧血~,鹿児島県医師会報 平成28年9月号,65-67.2016
2.張替秀郎:貧血-診断と治療のアプローチ-,日内会誌 104:567-571.2015

|
|
このサイトの文章、画像などを許可なく保存、転載する事を禁止します。
(C)Kagoshima City Medical Association 2016 |